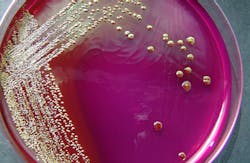
E. coli in petri dish E. coli in petri dish

National Advisory Committee on Microbiological Criteria for Foods restarts food safety work
The U.S. Department of Agriculture's Food Safety and Inspection Service (FSIS) on Jan. 28 announced the re-chartering of the National Advisory Committee on Microbiological Criteria for Foods (NACMCF) and the addition of 22 new members.
The committee is charged with providing recommendations to the Secretaries of Agriculture and Health and Human Services (HHS) on microbiological criteria by which the safety and wholesomeness of food can be assessed, including criteria for microorganisms that indicate whether foods have been adequately and appropriately processed.
"NACMCF's work provides FSIS and the Food and Drug Administration (FDA) with a valuable resource for obtaining external expert advice on scientific and technical food safety issues for our nation's food safety programs," said FSIS Administrator Al Almanza. "Re-chartering this committee benefits the public interest and fulfills statutory responsibilities."
RELATED: Utah meat packing company recalls beef products due to possible E. coli contamination
The committee membership consists of scientists from academia, industry, other organizations, and federal and state government as well as one individual affiliated with a consumer group, who is serving in a representational capacity. NACMCF members are appointed by the USDA Secretary in consultation with the Secretary of HHS with advice on membership from the Department of Commerce's National Marine Fisheries Service, the Department of Defense's Defense Logistics Agency, and the Department of Health and Human Services' Centers for Disease Control and Prevention (CDC).
Established in 1988, NACMCF formulates positions on the development of microbiological criteria, the review and evaluation of epidemiological and risk assessment data and methodologies for assessing microbiological hazards in foods. The committee's work also assists the CDC and the Departments of Commerce and Defense. The committee is the outcome of a 1985 report of the National Academy of Sciences Committee on Food Protection, Subcommittee on Microbiological Criteria.
The current charter for the NACMCF and a list of the 22 newly appointed and eight returning members can be viewed here.